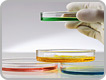

About JASA

JASA is an international scientific journal edited and published by AENSI Publications, Jordan. JASA exists to publish results of research in the area of appLIED SCIENCE AND AGRICULTURE. Papers are welcomed from both developed and developing countries describing original investigations of interest to those engaged in scientific research. The material should not have been previously published elsewhere. Review articles on a particularly hot subject may be suggested to the Editor-in-Chief. Book reviews, news of international meetings and activities, letters to the editors and editorial notes will also BE published at the editors' discretion.
Editor in Chief
Dr. Abdel Rahman M. Al-Tawaha
THOMSON REUTERS
Zoological Record Online
EBSCO HOST
Journal Seek
Ulrich's Periodicals Directory
CABI
complete list
Editorial Board
Prof. Dr. Kyung-Dong Lee, Korea
Prof. Dr. Mohammed Rahmatullah, Bangladesh
Prof. Dr. Abdul Haseeb Ansari, Malaysia
Dr. Anuchit Uchaipichat, Thailand
Dr. Bob Redden, Australia
Dr. Abu Umar Faruq Ahmad, Australia
Dr. Mohd Mustafa Al Bakri Abdullah, Malaysia
Dr. Sarwoko Mangkoedihardjo, Indonesia
Dr. Shyam Yadav, Afghanistan
Complete list
Submission Information
submit your research Please submit your manuscripts to the following email addresses
submit your research Please submit your manuscripts to the following email addresses
Tawahaagronomist@yahoo.com
 instructions Authors must fully understand and agree with instructions and note. see details
instructions Authors must fully understand and agree with instructions and note. see details